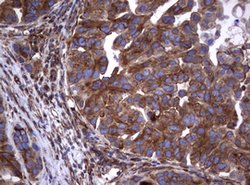
TNFRSF8 Mouse anti-Human, Clone: OTI1C6, lyophilized, TrueMAB 100 &mu;g;
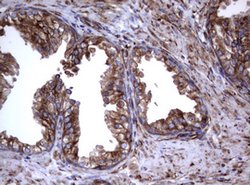
TNFRSF8 Mouse anti-Human, Clone: OTI1C6, lyophilized, TrueMAB 100 &mu;g;
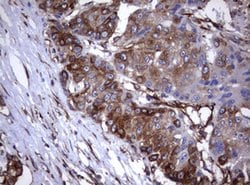
TNFRSF8 Mouse anti-Human, Clone: OTI1C6, lyophilized, TrueMAB 100 &mu;g;

Learn More
TNFRSF8 Mouse anti-Human, Clone: OTI1C6, lyophilized, TrueMAB™
Mouse Monoclonal Antibody
Brand: Origene Technologies CF801630

Description
Reconstitute with PBS (pH 7.3) and recommend to perform another round of desalting process using Product No. 7KMWCO
CD30 (Ki-1, TNF Receptor Superfamily Member 8) is a type I transmembrane glycoprotein of the TNF receptor superfamily. CD30 was originally identified as a cell surface antigen of Hodgkins and Reed-Sternberg cells using monoclonal antibody Ki-1. The ligand for CD30 is CD30L (CD153). The binding of CD30 to CD30L mediates pleiotropic effects including cell proliferation, activation, differentiation, and apoptotic cell death. CD30 has a critical role in the pathophysiology of Hodgkin′s disease and other CD30+ lymphomas. CD30 acts as a costimulatory molecule in thymic negative selection. In addition to its expression on Hodgkin′s and Reed-Sternberg cells, CD30 is also found in some non-Hodgkin′s lymphomas (including Burkitt′s lymphomas), virus-infected T and B cells, and on normal T and B cells after activation. In T cells, CD30 expression is present on a subset of T cells that produce Th2-type cytokines and on CD4+/CD8+ thymocytes that co-express CD45RO and the IL4 receptor. Soluble form of CD30 (sCD30) serves as a marker reflecting Th2 immune response. TRAF2 and TRAF5 can interact with this receptor, and mediate the signal transduction that leads to the activation of NF-kappaB. CD30 is a positive regulator of apoptosis, and has been shown to limit the proliferative potential of autoreactive CD8 effector T cells and protect the body against autoimmunity. Two alternatively spliced transcript variants of this gene encoding distinct isoforms have been reported. CD30 is expressed by mononuclear cells in Hodgkin′s lymphoma, Reed Sternberg cells and most Anaplastic Large Cell Lymphomas (ALCL). CD30 is also expressed by embryonal carcinomas.Specifications
| TNFRSF8 | |
| Monoclonal | |
| Unconjugated | |
| TNFRSF8 | |
| CD30, D1S166E, Ki-1 | |
| Mouse | |
| Affinity Chromatography | |
| RUO | |
| 943 | |
| -20° C, Avoid Freeze/Thaw Cycles | |
| Lyophilized |
| Flow Cytometry, Immunohistochemistry (Paraffin), Western Blot | |
| OTI1C6 | |
| PBS with 8% trehalose and no preservative; pH 7.3 | |
| P28908 | |
| TNFRSF8 | |
| Human recombit protein fragment corresponding to amino acids 19-379 of human TNFRSF8 produced in E.coli. | |
| 100 μg | |
| Primary | |
| Human | |
| Antibody | |
| IgG1 |
The Fisher Scientific Encompass Program offers items which are not part of our distribution portfolio. These products typically do not have pictures or detailed descriptions. However, we are committed to improving your shopping experience. Please use the form below to provide feedback related to the content on this product.